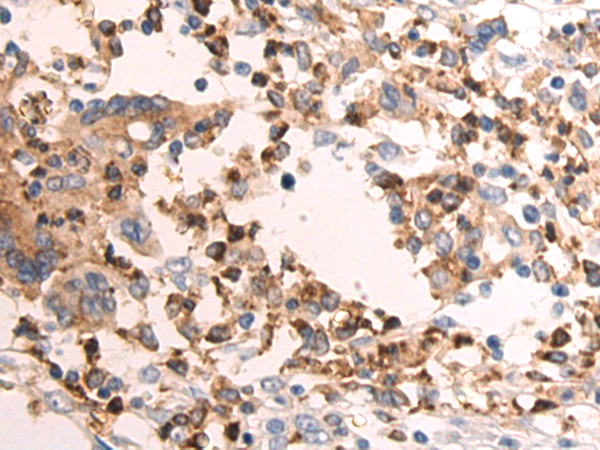

-
分类: 科研抗体货号: P07428别名: HAR; XLKD1; LYVE-1; CRSBP-1应用: WB,IHC反应种属: Human
-
分类: 科研抗体货号: P07447别名: REC, C20orf154, dJ967N21.5应用: WB反应种属: Human, Mouse, Rat
-
分类: 科研抗体货号: P07427别名: LZM; LYZF1应用: WB,IHC反应种属: Human, Mouse
-
分类: 科研抗体货号: P07446别名: HCC5, P1.h, RLFB, P1-MCM3应用: WB,IHC反应种属: Human, Mouse
-
分类: 科研抗体货号: P07426别名: ECI; TCI应用: WB,IHC反应种属: Human, Mouse, Rat
-
分类: 科研抗体货号: P07445别名: MCM2, CDC47, P85MCM, P1CDC47, PNAS146, P1.1-MCM3应用: WB,IHC反应种属: Human, Mouse
-
分类: 科研抗体货号: P07425别名: PARK8; RIPK7; ROCO2; AURA17; DARDARIN应用: IHC反应种属: Human
-
分类: 科研抗体货号: P07442别名: BM28; CCNL1; CDCL1; cdc19; D3S3194; MITOTIN应用: IHC反应种属: Human, Mouse
-
分类: 科研抗体货号: P07424别名: ST7应用: IHC反应种属: Human, Mouse
-
分类: 科研抗体货号: P07441别名: Mis5; P105MCM; MCG40308应用: WB,IHC反应种属: Human, Mouse, Rat

鄂公网安备42018502007531号
鄂公网安备42018502007531号

